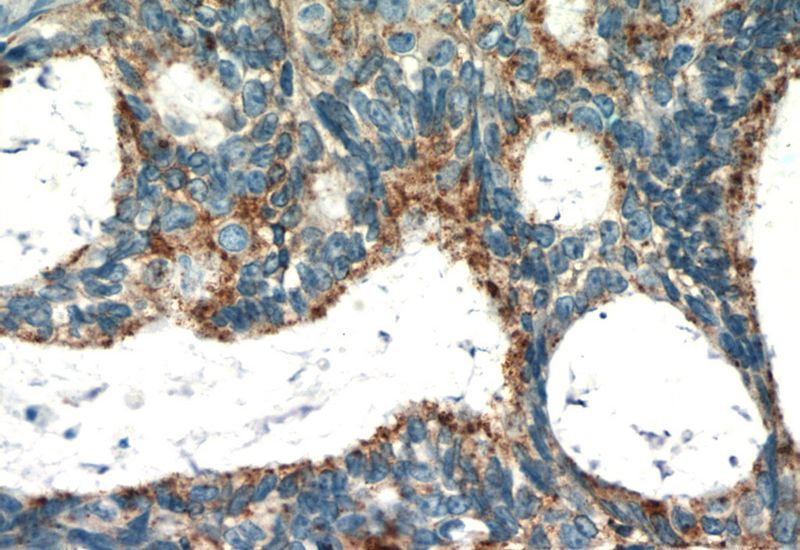
Immunohistochemistry of paraffin-embedded human ovary tumor slide using Catalog No:114479(RASGRP3 Antibody) at dilution of 1:50

-
Product Name
RASGRP3 antibody
- Documents
-
Description
RASGRP3 Rabbit Polyclonal antibody. Positive IHC detected in human ovary tumor tissue. Positive WB detected in RAW264.7 cells, PC-3 cells. Observed molecular weight by Western-blot: 70 kDa
-
Tested applications
ELISA, WB, IHC
-
Species reactivity
Human; other species not tested.
-
Alternative names
GRP3 antibody; KIAA0846 antibody; Ras guanyl releasing protein 3 antibody; RASGRP3 antibody
-
Isotype
Rabbit IgG
-
Preparation
This antibody was obtained by immunization of RASGRP3 recombinant protein (Accession Number: XM_011532748). Purification method: Antigen affinity purified.
-
Clonality
Polyclonal
-
Formulation
PBS with 0.02% sodium azide and 50% glycerol pH 7.3.
-
Storage instructions
Store at -20℃. DO NOT ALIQUOT
-
Applications
Recommended Dilution:
WB: 1:200-1:2000
IHC: 1:20-1:200
-
Validations

RAW264.7 cells were subjected to SDS PAGE followed by western blot with Catalog No:114479(RASGRP3 antibody) at dilution of 1:800

Immunohistochemistry of paraffin-embedded human ovary tumor slide using Catalog No:114479(RASGRP3 Antibody) at dilution of 1:50
Immunohistochemistry of paraffin-embedded human ovary tumor slide using Catalog No:114479(RASGRP3 Antibody) at dilution of 1:50
-
Background
RAS guanyl releasing protein 3 (RasGRP3) is a member of the RasGRP family and is able to promote guanine nucleotide exchange of Ha-Ras, R-Ras and Rap1 (PMID: 9582122). RasGRP3 is involved in a diverse range of important biological processes. RasGRP3 has emerged as an important mediator of signaling downstream from receptor coupled phosphoinositide turnover in B and T cells. Overexpression of RasGRP3 is commonly associated with many malignancies, such as pre-Bcell leukemia, Burkitt’s lymphoma and natural killer-like T-cell leukemia. Recently, it has been reported that upregulation of RASGRP3 expression in prostate cancer correlates with aggressive capabilities and predicts biochemical recurrence after radical prostatectomy (PMID: 24418912).
-
References
- Zeng X, Hu Z, Wang Z. Upregulation of RASGRP3 expression in prostate cancer correlates with aggressive capabilities and predicts biochemical recurrence after radical prostatectomy. Prostate cancer and prostatic diseases. 17(2):119-25. 2014.
- Lv L, Li X, Liu G. Production and immunogenicity of chimeric virus-like particles containing the spike glycoprotein of infectious bronchitis virus. Journal of veterinary science. 15(2):209-16. 2014.
Related Products / Services
Please note: All products are "FOR RESEARCH USE ONLY AND ARE NOT INTENDED FOR DIAGNOSTIC OR THERAPEUTIC USE"
